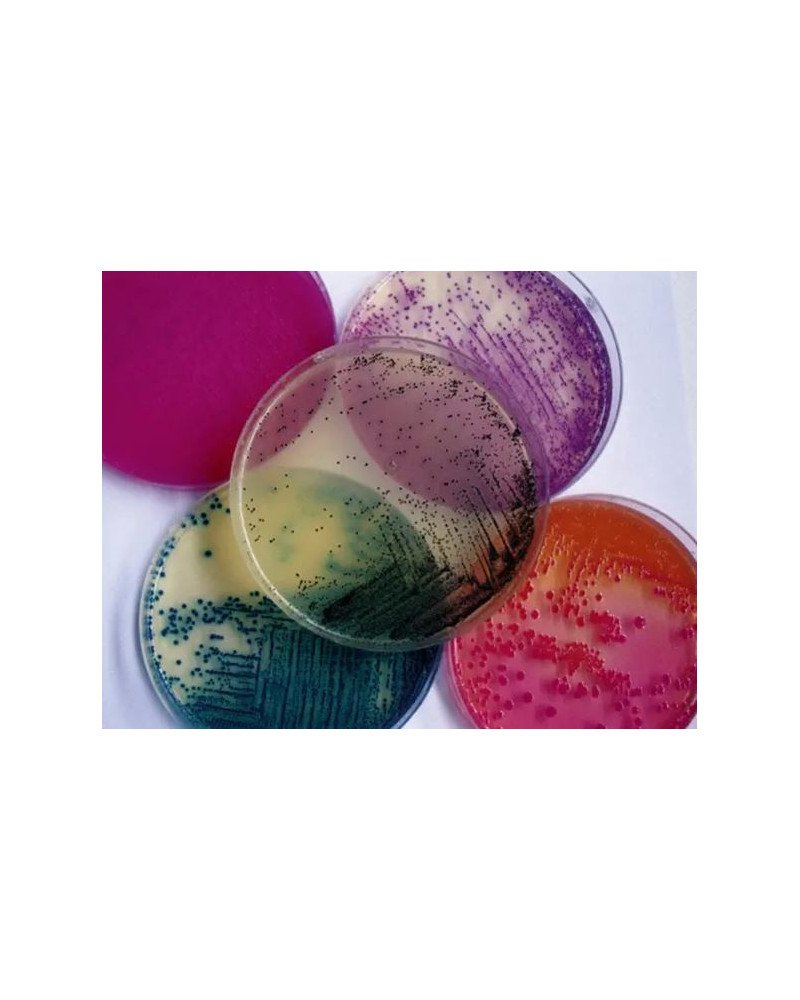
Gélose de CLED 20PLT

Gélose de CLED 20PLT
SOC-201807022
54,30 € HT
65,16 € TTC
TTC
Livraison entre 3 et 4 jours
Gélose de CLED 20PLT
CLED Agar est recommandé pour l'isolement, le dénombrement et l'identification d'agents pathogènes urinaires à partir de la fermentation du lactose.
 Des milliers de références
Des milliers de références
de marques au meilleur prix
 Livraison gratuite dès 125€
Livraison gratuite dès 125€
en France métropolitaine
 Paiements sécurisés
Paiements sécurisés
CB & Paypal
 Une équipe dédiée
Une équipe dédiée
Service client gratuit et personnalisé
Gélose de CLED 20PLT
CLED Agar est recommandé pour l'isolement, le dénombrement et l'identification d'agents pathogènes urinaires à partir de la fermentation du lactose.
SOC-201807022
Fiche technique
- delais
- 48 heures
- Demande de devis
- Allowed to Quote Mode
- Conformité CE
- Conformité NF
- Garantie
- Produit gynemat
- Hide from HTML Sitemap